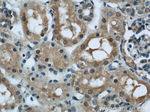
PFKFB3 Antibody in Immunohistochemistry (Paraffin) (IHC (P))

Search
Proteintech
PFKFB3 Polyclonal Antibody
{{$productOrderCtrl.translations['antibody.pdp.commerceCard.promotion.promotions']}}
{{$productOrderCtrl.translations['antibody.pdp.commerceCard.promotion.viewpromo']}}
{{$productOrderCtrl.translations['antibody.pdp.commerceCard.promotion.promocode']}}: {{promo.promoCode}} {{promo.promoTitle}} {{promo.promoDescription}}. {{$productOrderCtrl.translations['antibody.pdp.commerceCard.promotion.learnmore']}}
产品信息
13763-1-AP
种属反应
已发表种属
宿主/亚型
分类
类型
抗原
偶联物
形式
浓度
规格
纯化类型
保存液
内含物
保存条件
运输条件
产品详细信息
This antibody is specific to PFKFB3.
Immunogen sequence: HVQPRTIYL CRHGENEHNL QGRIGGDSGL SSRGKKFASA LSKFVEEQNL KDLRVWTSQL KSTIQTAEAL RLPYEQWKAL NEIDAGVCEE LTYEEIRDTY PEEYALREQD KYYYRYPTGE SYQDLVQRLE PVIMELERQE NVLVICHQAV LRCLLAYFLD KSAEEMPYLK CPLHTVLKLT PVAYGCRVES IYLNVESVCT HRERSEDAKK GPNPLMRRNS VTPLASPEPT KKPRINSFEE HVASTSAALP SCLPPEVPTQ LPGQNMKGSR SSADSSRKH (243-520 aa encoded by BC040482)
靶标信息
The protein encoded by this gene belongs to a family of bifunctional proteins that are involved in both the synthesis and degradation of fructose-2,6-bisphosphate, a regulatory molecule that controls glycolysis in eukaryotes. The encoded protein has a 6-phosphofructo-2-kinase activity that catalyzes the synthesis of fructose-2,6-bisphosphate (F2,6BP), and a fructose-2,6-biphosphatase activity that catalyzes the degradation of F2,6BP. This protein is required for cell cycle progression and prevention of apoptosis. It functions as a regulator of cyclin-dependent kinase 1, linking glucose metabolism to cell proliferation and survival in tumor cells. Several alternatively spliced transcript variants encoding different isoforms have been found for this gene.
仅用于科研。不用于诊断过程。未经明确授权不得转售。
生物信息学
蛋白别名: 6-biphosphatase 3; 6-phosphofructo-2-kinase/ fructose-2,6-bisphosphatase; 6-phosphofructo-2-kinase/fructose-2,6-bisphosphatase 3; 6PF-2-K/Fru-2,6-P2ase 3; 6PF-2-K/Fru-2,6-P2ASE brain-type isozyme; 6PF-2-K/Fru-2,6-P2ase brain/placenta-type isozyme; Fructose-2; fructose-6-phosphate,2-kinase/fructose-2, 6-bisphosphatase; inducible 6-phosphofructo-2-kinase; inducible 6-phosphofructo-2-kinase/fructose-2,6-bisphosphatase; iPFK-2; PFK-2/FBPase-2; PFK/FBPase 3; RB2K; Renal carcinoma antigen NY-REN-56; RP11-298K24.3; unnamed protein product
基因别名: E330010H22Rik; iPFK-2; IPFK2; PFK2; PFKFB3; uPFK-2
UniProt ID: (Human) Q16875, (Rat) O35552
Entrez Gene ID: (Human) 5209, (Rat) 117276, (Mouse) 170768